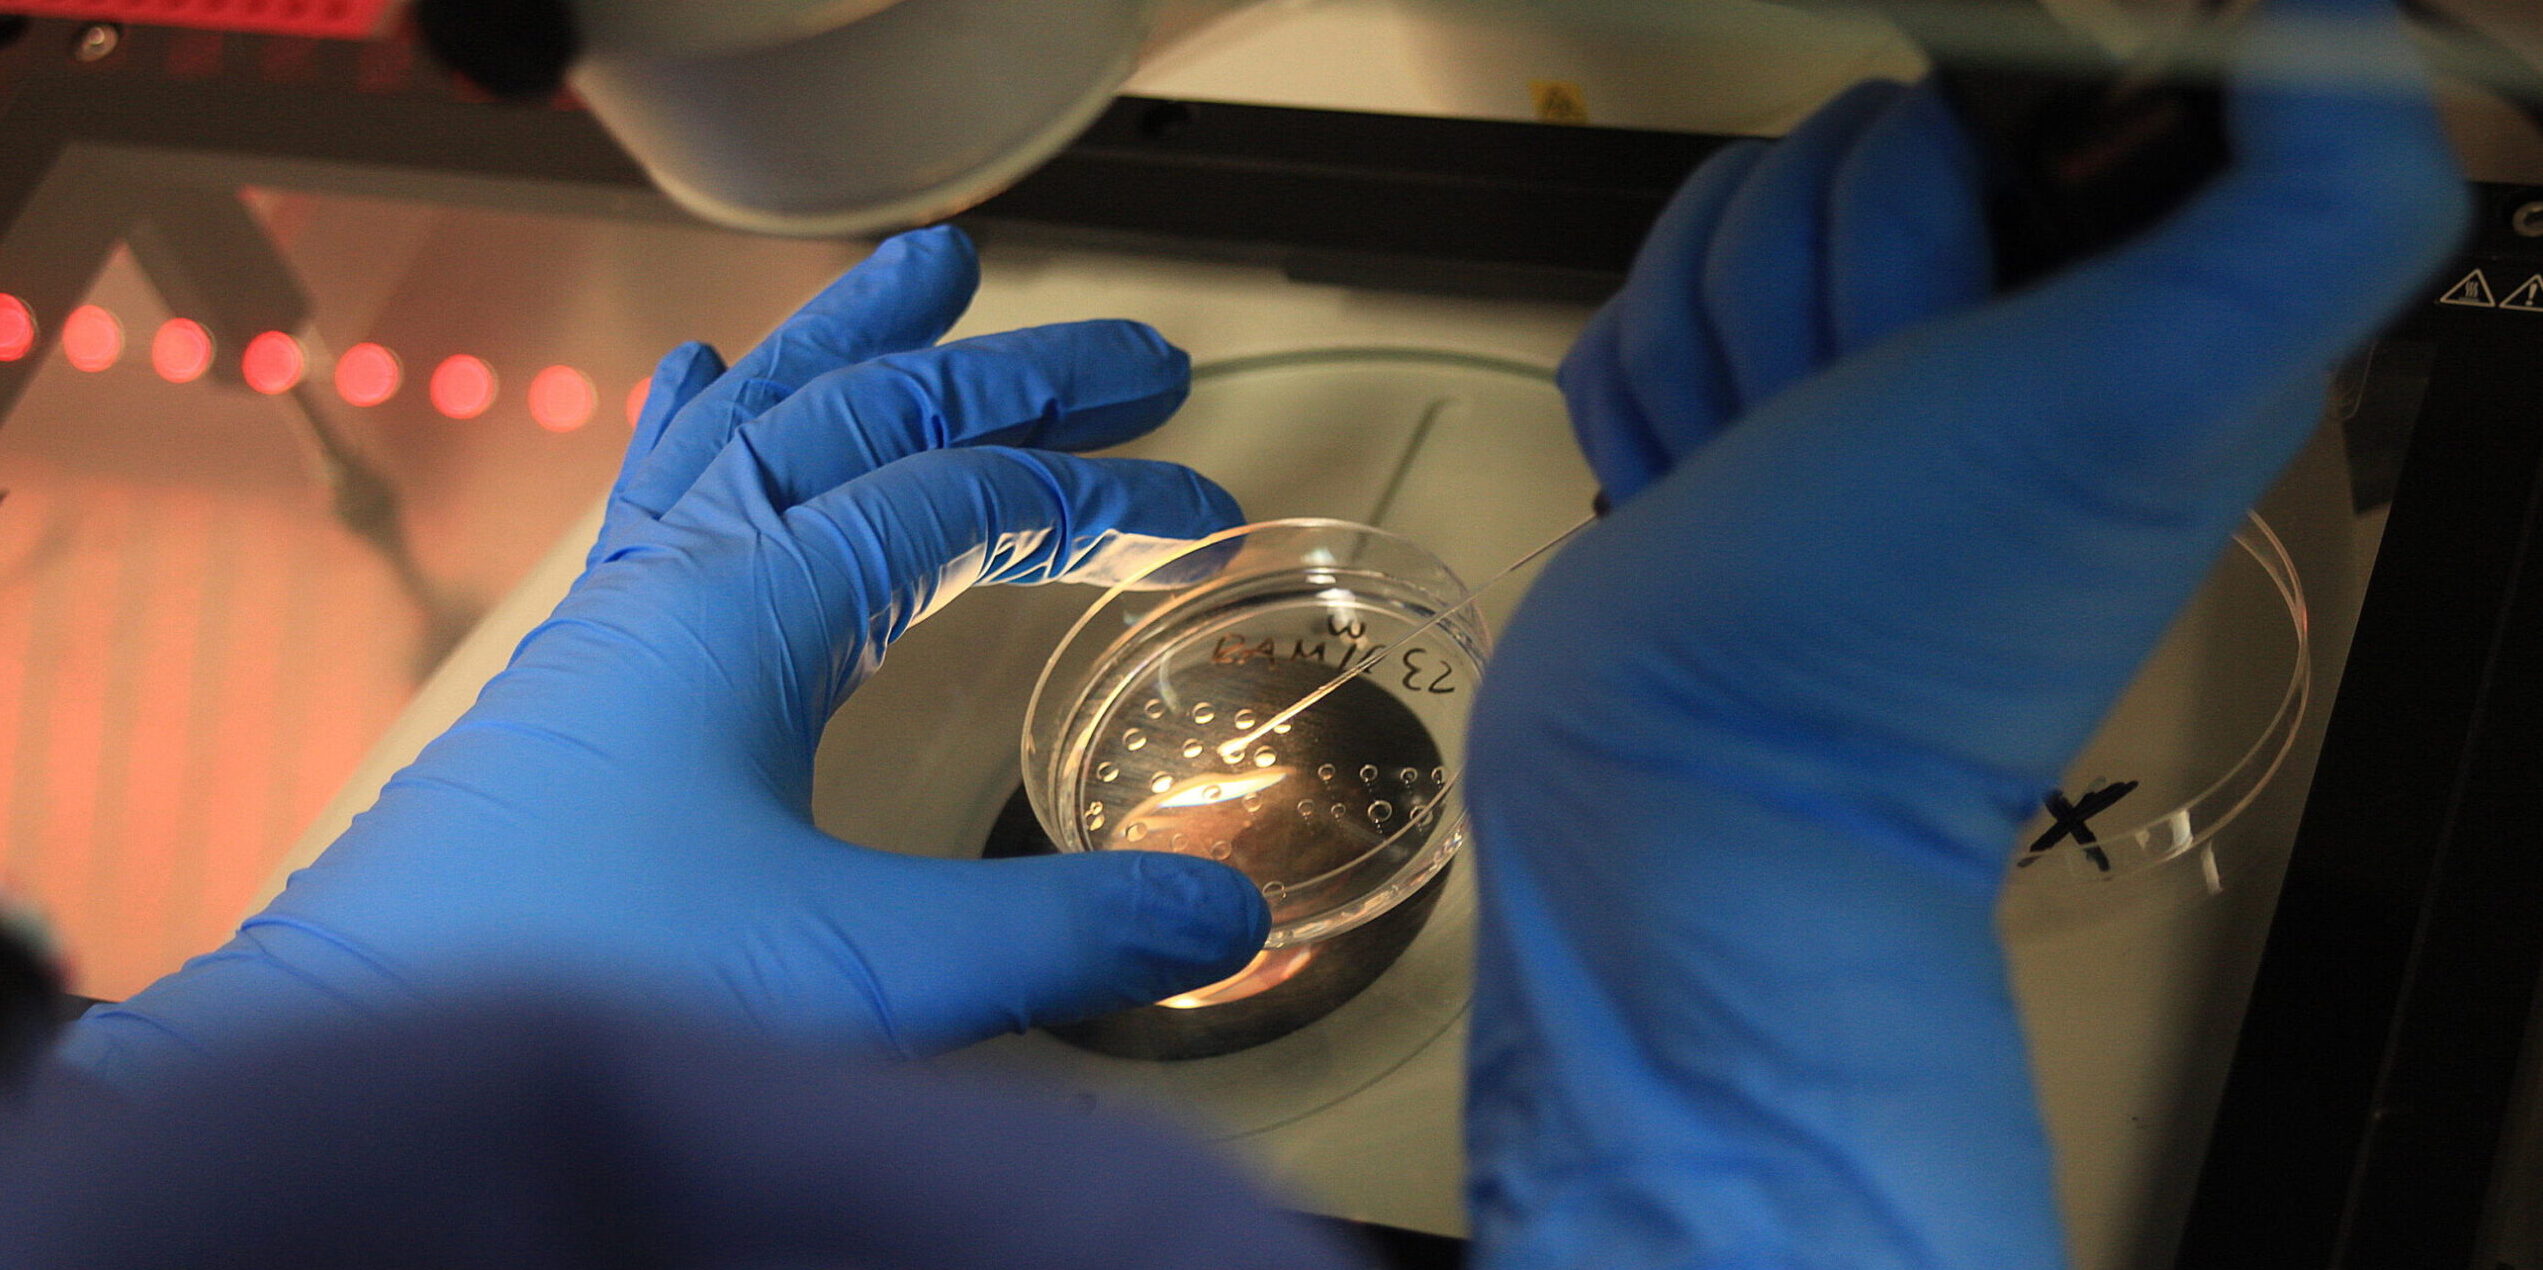

Di recente, un gruppo di ricercatori dell’Università di Kyoto e del Weizmann Institute of Science ha pubblicato su Nature uno studio che descrive nuovi progressi nella generazione in vitro di cellule germinali umane a partire da cellule staminali pluripotenti. La notizia ha riacceso il dibattito su una delle frontiere più delicate della biologia contemporanea: la possibilità di creare ovociti e spermatozoi umani in laboratorio, un processo noto come in vitro gametogenesis (IVGa).
In modelli animali – in particolare nel topo – la IVGa ha già permesso la nascita di cuccioli vitali da gameti completamente artificiali. Ma il passaggio all’uomo resta ancora lontano: la biologia della meiosi umana, cioè la divisione che riduce a metà il patrimonio genetico, è estremamente complessa e difficilmente replicabile in vitro.
Ciononostante, la prospettiva di ottenere gameti umani “da zero” affascina molti ricercatori, poiché potrebbe rivoluzionare la medicina della fertilità e ridefinire i confini della riproduzione umana.
Sul piano clinico, la IVGa potrebbe un giorno offrire soluzioni a persone affette da infertilità irreversibile, consentire la genitorialità a coppie dello stesso sesso o preservare la fertilità in età avanzata. Tuttavia, dietro questa promessa si nasconde una sfida antropologica profonda: la possibilità di separare la generazione dalla corporeità personale.
La visione personalista ricorda che la persona umana non è il risultato di un processo tecnico, ma il frutto di una relazione interpersonale incarnata, in cui libertà, affettività e corporeità si intrecciano. La nascita, in questa prospettiva, non è un evento puramente biologico, ma un atto relazionale, che mette in comunione due soggetti e si apre a un terzo. La produzione artificiale di gameti introduce invece la logica della “fabbricazione”: la vita umana rischia di essere percepita come il risultato di un procedimento tecnico, piuttosto che come dono.
L’etica personalista riconosce il valore della ricerca scientifica e della cura dell’infertilità, ma richiama a un discernimento critico: non ogni possibilità tecnica coincide con un bene umano.
Nel caso della IVGa, emergono almeno tre ordini di questioni:
a) la sperimentazione su embrioni umani, inevitabile per testare la funzionalità dei gameti sintetici, che comporterebbe la distruzione di vite umane allo stadio iniziale;
b) la genitorialità disincarnata o indifferenziata, che potrebbe derivare dall’uso di gameti derivati da cellule di uno stesso individuo o da due persone dello stesso sesso;
c) la logica di controllo genetico, favorita dalla possibilità di selezionare e combinare gameti in modo programmato.
In ciascuno di questi casi, l’essere umano viene trattato come oggetto di manipolazione, piuttosto che come soggetto di relazione. Il corpo, che nella visione personalista è parte integrante della persona, viene ridotto a materia prima biologica disponibile, e l’atto generativo si separa dalla sua dimensione etica e simbolica.
La prudenza, virtù cardine della bioetica personalista, non è chiusura al progresso, ma discernimento morale. Essa impone di chiedersi non solo “se” possiamo fare qualcosa, ma “perché” e “a quale fine” la facciamo.
Ogni innovazione deve essere misurata sulla dignità della persona, che precede e fonda ogni diritto alla genitorialità. Il desiderio di avere un figlio, pur legittimo, non può trasformarsi in diritto assoluto a “produrlo” con qualsiasi mezzo.
Finché la ricerca sulla gametogenesi in vitro non potrà garantire la piena tutela di ogni soggetto coinvolto – dai gameti all’embrione, dai genitori ai figli futuri – il suo impiego clinico dovrà rimanere nel campo della sperimentazione di base (non su modello umano), sorretto da rigorosi limiti etici e giuridici.
Probabilmente, la IVGa rappresenta una delle più audaci avventure della biomedicina contemporanea. Ma la misura del progresso non risiede nella capacità di superare i limiti naturali, bensì nella sapienza di riconoscerli come parte del mistero della persona umana.
La scienza è autenticamente umana quando non si riduce a potere sul vivente, ma rimane “a servizio della vita”. Solo in questa direzione la generazione, anche quando sostenuta dalla tecnica, potrà continuare a essere un atto profondamente umano.




